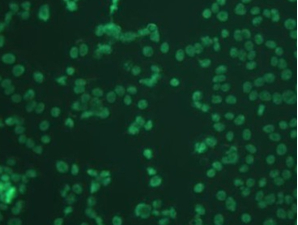

细胞污染问题分析解决
细胞转染时,细胞状态的好坏对转染效率有很大影响。细胞污染可能会导致细胞死亡,本文主要总结了细胞培养中常见污染现象和解决方法。
凡是对细胞生长有危害的成分或者造成细胞不纯的异物都视为污染。细胞污染根据污染源可以分为化学污染,物理污染和生物污染。本文主要描述微生物污染的现象及解决方法
微生物污染
1. 细菌:细菌污染常见的有大肠杆菌,葡萄球菌等。细菌污染较易发现,在普通倒置显微镜下为黑色细沙状,培养液一般会在短时间内变黄,有时静置的培养液不混,稍加震荡,变会有很多混浊物漂起。显微镜下可见培养液中有大量圆球状颗粒物漂浮,有时在细胞表面及周围有大量细菌存在,细胞停止生长并有中毒表现。
处理:① 在培养液中加入相应的抗生素,能够预防绝大多数的细菌污染
②保证器皿、水充分灭菌,空气无菌,同时保证灭菌压力。
2、霉菌:霉菌的污染多数是白色念珠菌, 曲霉菌,酵母菌等。霉菌污染后培养液短期内依旧清亮不变浑浊,倒置显微镜下可看见细胞之间有交错的丝状,树枝状菌丝,漂浮在培养液中。念珠菌呈卵圆状,在细胞周边生长。细胞被霉菌污染后,仍可生长,长时间细胞的活力状态会变差。

处理:先确定污染物的种类:细菌、真菌还是支原体。如果是霉菌污染。迅速将污染细胞与正常细胞系隔离,并对实验中所用过的所有器皿工具消毒
3、支原体:支原体的大小介于细菌和病毒之间,是一种独立生活的微生物。对热敏感,对一般抗生素不敏感。支原体的形态多变,多吸附在细胞表面和细胞之间。电镜下观察,中心有高密度的密集颗粒,横断面与细胞微绒毛相似。
因国内的血清很多数都没有做支原体阴性检测,而支原体又是牛血清中最常见的微生物之一。支原体污染细胞后,培养液轻微发生混浊.但细胞变化不显著,在细胞逐渐的培养中,细胞会慢慢死亡。
支原体污染检测:
荧光染色法:DNA和与DNA特异性结合的荧光染料结合,使得支原体的DNA着色,然后用荧光显微镜观察。镜下支原体为散在于细胞同围或附于细胞膜表面的亮绿色小点。
解决:① 抗生素排除法:支原体污染预防比解决好。如果不小心污染后,可加入高浓度抗生素(常规使用的5倍浓度)作用24-48小时,再换入常规培养液,但该法不保证有效。推荐用量:庆大霉素 200ug/ml ,四环素10ug/ml ,卡那霉素50ug/ml 。
2 加温除菌:支原体不耐热,可以对支原体污染的细胞热处理除菌。将支原体污染的细胞放置41度中作用10小时可杀死支原体。因高温对细胞本身也会产生一定影响,故热处理前需先进行预实验,确定对细胞影响最小而能最大程度的杀死支原体的时间。
4、黑蛟虫:黑胶虫污染后细胞中出现小黑点,高倍镜下可看见不规则的运动。培养液浑浊不明显,对细胞生长状态无太大影响。
解决:如果细胞出现黑胶虫污染,可增加细胞的接种密度,提高细胞存活率。当细胞生长状态很好时,黑胶虫的数量会降低。细胞培养过程中坚持要每天换液,并用缓冲液冲洗,能够大大降低黑胶虫的数量,可最终消失,偶尔在镜下可见个别小黑点,但整体细胞培养和后续的细胞转染(https://www.detaibio.com/mammalian-cell-stable-cell-line.html)无影响。
细胞培养箱染菌清洗方法
用硫酸铜溶液擦拭CO2孵箱内,再把水盘里也加上饱和量的硫酸铜。或者在培养箱的托盘加入饱和的消毒磷酸氢二钠高盐液体,可以防止霉菌污染。
CO2孵箱被霉菌污染后,可把所有细胞暂时转移,采用过氧乙酸擦洗孵箱(包括隔板,箱壁)。并把过氧乙酸放置在孵箱内一个小时,使其蒸汽弥漫。待过氧乙酸的气味消散后,再移入细胞。孵箱应定期清洁(2月左右)。
其它培养箱清洗方法是:用84液擦洗-清水擦洗-75%酒精擦洗-紫外灯照。
预防霉菌污染,可在培养基里加3u/ml的两性霉素或制霉菌素或放线菌素D或双抗;但细胞一旦污染,制霉菌素或放线菌素D或双抗都无法弥补,舍弃被污染细胞,并将环境彻底消毒。如果所有细胞都污染,可能是整体系统污染,检查所有培养基和器材,并重新灭菌。针对个别污染,首先考虑操作问题,注意操作规范。
更多关于分子生物学和蛋白表达方面的资料请访问https://www.detaibio.com/material-downloads.html
